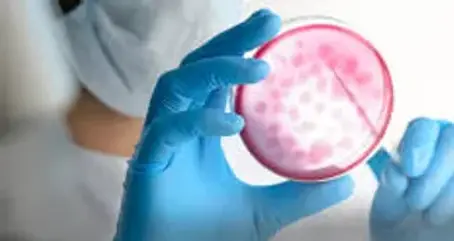

Лучшие инфекционисты в Санкт-Петербурге, руководство по выбору
Инфекционист — это врач, который выявляет, лечит и предотвращает инфекционные заболевания. Это патологии, вызванные попаданием в организм возбудителей из внешней среды. Чаще всего это вирусы, бактерии и грибки.
Научные сферы, связанные с работой врача-инфекциониста:
эпидемиология — изучение эпидемий и пандемий с целью их контроля и предотвращения;
микробиология — работа с микроскопическими организмами, в том числе представляющими опасность для человека.
Инфекционисты стараются обезопасить пациентов из групп риска. Консультируя тех, кто уже заболел, врачи принимают меры, чтобы не допустить распространения инфекции.

Как правильно выбрать хорошего инфекциониста?
Несколько рекомендаций для пациентов, которые ищут специалиста для консультации, обследования и лечения:
Инфекционист — это прежде всего врач. Поэтому важно убедиться, что он имеет профессиональное медицинское образование.
Чем больше стаж, тем лучше. Лучше обращаться к врачу, который работает по основной специальности уже два-три года, а в идеале — лет пять.
В случае с инфекциями практика должна дополняться постоянным обучением. Повышение квалификации позволяет инфекционисту поддерживать знания в актуальном виде. Иначе он не будет осведомлен о новых опасных инфекциях и методах борьбы с ними.
Для профессионала, который работает с инфекционными болезнями, нет такого понятия, как мелочь. Он будет задавать много вопросов. Некоторым пациентам это даже покажется дотошным. Но только так можно удостовериться в отсутствии дополнительных рисков.
Опытный инфекционист не полагается на предположения или слухи. Ему нужна предельно точная информация, поэтому он проведет детальный осмотр и назначит пациенту необходимые анализы.
Вежливость и тактичность — также важные черты врача, который работает с опасными болезнями. Убедиться в этом можно уже при визите в кабинет. А заодно посмотреть, соблюдены ли там меры защиты, обеспечены ли стерильные условия.
Профессиональный врач, с одной стороны, не занимается саморекламой; с другой — не стесняется ответить на вопросы о своем образовании. Для компетентного инфекциониста важна в первую очередь его работа, которая помогает победить возбудителей болезни и предотвратить негативные последствия.

С какими проблемами обращаются к инфекционисту?
У каждой инфекции свои симптомы. Однако насторожить пациента должны следующие признаки:
температура тела переходит предел +37,8 °C, появляется лихорадка, обычно с головной болью и сильным ознобом;
кружится голова, мутнеет сознание, возможны галлюцинации;
нарушается пищеварение, возникают диарея и тошнота;
пациент быстро устает, испытывает слабость, нередко с апатией;
становится тяжело дышать, возникают одышка, кашель, насморк;
по коже распространяется сыпь без признаков ожога или аллергии;
отекают, припухают отдельные суставы или мышцы, возможны судороги;
внезапно, без явной причины ухудшаются зрение, слух, обоняние, вкусовая и тактильная чувствительность;
нарушается сердечный ритм, чувствуется боль в груди, возможен синюшный цвет кожи на лице, руках и ногах;
увеличиваются, припухают, болят лимфоузлы;
цвет кожи приобретает желтоватый оттенок.
Перечисленные признаки возникают по множеству причин, в том числе из-за опасных инфекций. Поэтому при появлении любого из них, а тем более нескольких, следует поскорее обратиться к врачу. По возможности лучше вызвать «скорую».
К инфекционисту обращаются люди, которые собираются по работе, учебе или в рамках турпоездки посетить другую страну с неблагоприятной эпидемиологической обстановкой. Также посещают этого врача пациенты, которые вернулись из другой страны или региона, после чего стали плохо себя чувствовать. Особенно если симптомы специфичны и не похожи на стандартную ОРВИ.
Топ лучших инфекционистов в Санкт-Петербурге — рейтинг 2026 года
В Санкт-Петербурге практикует боле�е 500 инфекционистов, они отличаются опытом, образованием, используемыми методиками лечения. Мы выбрали 10 лучших инфекционистов Санкт-Петербурга, ориентируясь в первую очередь на соотношение положительных и отрицательных отзывов о враче из свободных источников, опыт оказания медицинской помощи, основное и дополнительное образование, применяемые методы работы, виды оказываемых услуг (готовность оказать медицинскую помощь на дому), личные качества специалиста, его универсализм.
1. Майорова Светлана Олеговна — лучший инфекционист Санкт-Петербурга

Запись по телефону: +7 (812) 413-96-80
Адрес приема инфекциониста:
«Клиника АйДи»
г. Санкт-Петербург, ул.Ивана Черных, 25А
Стоимость приема инфекциониста:
от 4000 рублей
Майорова Светлана Олеговна — врач-инфекционист высшей категории с опытом работы более 25 лет. Кандидат медицинских наук.
Занимается диагностикой и лечением многочисленных инфекционных и паразитарных заболеваний. Проводит работу по предупреждению распространения инфекционных эпидемий.
Специализируется на лечении следующих заболеваний:
корь и краснуха;
менингококковая инфекция;
рожа;
холера, вызываемая бактерией Vibrio Cholerae;
малярия.
3. Сизова Натал�ия Владимировна

Запись по телефону: +7 (812) 413-96-80
Адрес приема:
«Клиника АйДи»
г. Санкт-Петербург, ул.Ивана Черных, 25А
Цена консультации инфекциониста:
от 5000 рублей
Сизова Наталия Владимировна — врач-инфекционист высшей категории с опытом работы более 40 лет. Доктор медицинских наук, доцент.
Антиретровирусная терапия, резистентность ВИЧ, коморбидные состояния при ВИЧ-инфекции.
2. Науменко Ви�талий Владимирович

Запись по телефону: +7 (812) 413-96-80
Адрес приема инфекциониста в клинике:
«Лазарет»
г. Санкт-Петербург, ул. 17-я линия Васильевского острова, д. 4
Стоимость консультации:
от 3500 рублей
Науменко Виталий Владимирович — врач-инфекционист со стажем работы более 11 лет.
Занимается диагностикой инфекционных болезней, назначает препараты для лечения болезни и наблюдает за их действием и возможными побочными эффектами. Проводит консультации и противоэпидемические мероприятия, с целью предупредить распространение инфекционных заболеваний среди здоровых людей.
Самостоятельный подбор инфекциониста
Если предложенные лучшие инфекционисты Санкт-Петербурга не подходят по различным причинам (стоимость услуг, загруженность врача или неудобное местоположение) - можно о�знакомиться с другими проверенными врачами, практикующими в Санкт-Петербурге и подобрать достойного специалиста.
Частые вопросы
Какие заболевания лечит инфекционист?
Перечисление всех патологий, которыми занимается данный специалист, составляет отдельный длинный перечень. Однако все они относятся к одной из следующих групп:
инфекции дыхательных путей — одни из самых агрессивных, поскольку передаются воздушно-капельным способом, хотя сюда же относятся острые респираторно-вирусные инфекции (ОРВИ), в быту часто называемые «обычной простудой»;
кишечные инфекции — передаются через еду, напитки, воду, а также при несоблюдении личной гигиены (так называемые болезни грязных рук);
кровяные инфекции — попадают в организм либо трансмиссивным путем (через укусы комаров, блох и других насекомых), либо через нестерильные иглы во время медицинских процедур и приема наркотиков;
инфекции наружных покровов — обычно передаются через непосредственный контакт (менее регулярно посредством предметов общего пользования), через кожу или слизистые оболочки, в частности вовремя полового контакта (ИППП).
В начале 2020-х наиболее актуальной для всего мира инфекцией стал коронавирус Covid-19. Хотя никуда не делись другие опасные заболевания, включая ВИЧ, гепатиты, гельминтоз, коклюш и многие другие болезни. Некоторые, такие как бубонная чума, сибирская язва, бешенство, представляют смертельную опасность, но не распространяются благодаря усилиям инфекционистов массово, как это было раньше.
Как подготовиться к приему инфекциониста?
Общие рекомендации для пациентов, которые собираются посетить данного специалиста:
Не употребять алкоголь и крепкий кофе, не курить, не ходить в баню или сауну хотя бы за один день до визита к врачу.
Исключить прием любых медикаментов. Если лекарства необходимы по назначению врача — обязательно сообщить инфекционисту, что это за препараты, как часто и в какой дозировке их приходится принимать.
Примерно за двенадцать часов до визита ограничить прием пищи и сильные физические нагрузки.
Тем, у кого уже есть подозрения на наличие той или иной инфекции, стоит ограничить контакты с другими людьми. Если симптомы прогрессируют и создают опасения за жизнь и здоровье пациента — необходимо вызвать «скорую». Ее работники примут решение об изоляции пациента.

Как проходит консультация у инфекциониста?
Общая схема действий при посещении кабинета данного специалиста:
Врач выслушивает жалобы, задает вопросы. Они касаются как истории болезни, так и последних событий: выезда в другие страны и регионы, контакта с потенциальными распространителями.
Инфекционист осматривает пациента, проводит пальпацию и инструментальное обследование. Сам он обязательно соблюдает меры защиты, предусмотренные медицинским стандартом.
Если необходимы срочные меры в связи с обнаружением опасной инфекции (изоляция, госпитализация, вакцинация) — врач сразу сообщает об этом и обращается к сотрудникам медучреждения.
Когда нет непосредственной угрозы жизни и здоровью пациента, но требуется уточнить диагноз, назначают дополнительные анализы, исследования.
Собрав всю информацию, врач ставит окончательный диагноз и дает рекомендации. Нередко требуется посещение профильного специалиста, исходя из обнаруженной патологии.
Если остались дополнительные вопросы — инфекционист отвечает на них. Его отдельная задача — обезопасить контактных лиц пациента от заражения болезнью.
Учитывая количество и разнообразие инфекций, в каждом случае требуется индивидуальный подход. Хотя, если речь идет об эпидемии или пандемии, для больших групп пациентов вырабатываются общие схемы решения проблемы — что было заметно, например, при росте числе заболевших Covid-19.
Какие анализы, исследования нужно сдать на приеме инфекциониста?
Установить и уточнить диагноз помогают:
общие, специфические анализы крови, включая иммуноферментный (ИФА);
исследования мочи, мокроты, мазков, кала (копрограмма);
забор и анализ спинномозговой жидкости;
полимеразная цепная реакция (ПЦР);
ультразвуковое исследования (УЗИ) проблемных органов;
рентгенография, компьютерная и магнитно-резонансная томография (КТ, МРТ);
радионуклидная диагностика (сцинтиграфия).
При необходимости назначаются и другие процедуры, включая анализы, направленные на выявление вполне конкретных возбудителей инфекции в организме.
Детский инфекционист: специфика работы
Специалист, который работает с детьми, особенно с малышами, берет на себя большую ответственность. Однако многое зависит и от его родителей? Несколько важных моментов, о которых следует помнить:
Задача родителей — максимально полно и честно отвечать на вопросы инфекциониста. Тем более что ребенок младшего возраста не может сам описать свое состояние.
Детское здоровье больше подвержено риску, чем у взрослых. Из-за этого, с одной стороны, к детям осторожнее применяют меры лечения; с другой — назначают более строгие меры профилактики.
Важно соблюдать плановую вакцинацию, которая проводится в детстве согласно действующей программе. Если ребенок по какой-то причине не получил плановую вакцину — об этом нужно сказать врачу в первую очередь.
Резюме
Современная медицина подразумевает максимально безопасные методы лечения и профилактики, в частности вакцинации. И у детей, и у взрослых снижаются риски благодаря компетентной работе инфекциониста. Что не менее важно, добросовестное отношение пациента (или его родителей) и профессионализм врача — способ минимизировать распространение особо заразных инфекций.
Информация о размещенных медицинских учреждениях, специалистах и врачах не является публичной офертой и является личным субъективным мнением авторов сайта. Подробная информация публикуется на официальных сайтах. Информация, представленная на сайте, не может быть использована для постановки диагноза, назначения лечения и не заменяет прием врача или специалиста.







